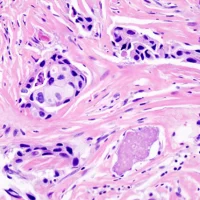
Anatomo-cyto-pathologie

Formations en biologie médicale pour biologistes et techniciens de laboratoire
Depuis 40 ans à vos côtés pour améliorer les pratiques de laboratoire et la fiabilité des analyses médicales.

Formation en biologie médicale certifiée Qualiopi et éligible DPC
Depuis près de 40 ans, Bioformation forme les professionnels de santé aux pratiques et innovations de la biologie médicale.
Certifié Qualiopi, notre organisme propose des formations prises en charge par les OPCO, dont certaines éligibles au DPC et financées par l’ANDPC.
Bioformation, acteur de référence en formation scientifique et médicale, allie expertise, innovation et transmission.


Devenir formateur
En quelques clics vous pourrez activer votre profil et commencer à recevoir nos offres.
Questions fréquentes
Bioformation propose plus de 100 formations spécialisées dans les domaines de la biologie médicale, de la biologie moléculaire, de la cytologie, de la microbiologie, de l'hémostase et de la biochimie. Ces programmes, animés par des experts scientifiques, permettent aux techniciens et biologistes médicaux de perfectionner leurs compétences et d'actualiser leurs connaissances.
Oui. Certifié Qualiopi, Bioformation garantit la qualité de ses formations, éligibles à une prise en charge par les OPCO.
De plus, plusieurs de nos programmes sont accrédités DPC, permettant une prise en charge par l'ANDPC pour les professionnels de santé concernés.
Les formations se déroulent en présentiel ou à distance, selon le thème et le profil des participants. Nos modules sont pensés pour allier théorie, pratique et cas concrets, afin de favoriser une application directe au laboratoire.
Nos formations s'adressent aux techniciens de laboratoire, biologistes médicaux, cadres de santé et professionnels en reconversion souhaitant approfondir leurs compétences dans les domaines scientifiques et techniques liés à la biologie médicale.
L'inscription s'effectue directement en ligne sur le site www.bioformation.fr
ou via votre service formation.
Nos conseillers pédagogiques vous accompagnent dans le choix du programme et dans les démarches de financement DPC ou OPCO.
40 ans d’expérience
Une expertise reconnue qui garantit la qualité et la fiabilité de chaque formation.
Présence nationale
Dans notre centre à Paris en présentiel ou à distance mais aussi partout en France dans vos locaux.
+ 200 programmes
Pour développer ses compétences scientifiques et techniques. Conception sur mesure possible.
Certifié Qualiopi & DPC
Une prise en charge facilitée grâce aux financements OPCO et ANDPC.